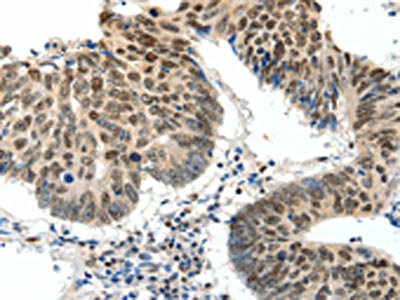

TOP2A Antibody
-
中文名稱:TOP2A兔多克隆抗體
-
貨號:CSB-PA062296
-
規格:¥1100
-
圖片:
-
The image on the left is immunohistochemistry of paraffin-embedded Human colon cancer tissue using CSB-PA062296(TOP2A Antibody) at dilution 1/30, on the right is treated with synthetic peptide. (Original magnification: ×200)
-
The image on the left is immunohistochemistry of paraffin-embedded Human ovarian cancer tissue using CSB-PA062296(TOP2A Antibody) at dilution 1/30, on the right is treated with synthetic peptide. (Original magnification: ×200)
-
-
其他:
產品詳情
-
Uniprot No.:
-
基因名:
-
別名:alpha isozyme antibody; ATP hydrolyzing DNA topoisomerase II alfa antibody; DNA gyrase antibody; DNA topoisomerase (ATP hydrolyzing) antibody; DNA topoisomerase 2 alpha antibody; DNA topoisomerase 2-alpha antibody; DNA topoisomerase II 170 kD antibody; DNA topoisomerase II alpha isozyme antibody; DNA topoisomerase II antibody; DNA Topoisomerase2 antibody; TOP 2A antibody; TOP2 antibody; TOP2A antibody; TOP2A_HUMAN antibody; Topoisomerase DNA II alpha 170kDa antibody; TP2A antibody
-
宿主:Rabbit
-
反應種屬:Human,Mouse,Rat
-
免疫原:Synthetic peptide of Human TOP2A
-
免疫原種屬:Homo sapiens (Human)
-
標記方式:Non-conjugated
-
抗體亞型:IgG
-
純化方式:Antigen affinity purification
-
濃度:It differs from different batches. Please contact us to confirm it.
-
保存緩沖液:-20°C, pH7.4 PBS, 0.05% NaN3, 40% Glycerol
-
產品提供形式:Liquid
-
應用范圍:ELISA,IHC
-
推薦稀釋比:
Application Recommended Dilution ELISA 1:2000-1:5000 IHC 1:50-1:200 -
Protocols:
-
儲存條件:Upon receipt, store at -20°C or -80°C. Avoid repeated freeze.
-
貨期:Basically, we can dispatch the products out in 1-3 working days after receiving your orders. Delivery time maybe differs from different purchasing way or location, please kindly consult your local distributors for specific delivery time.
-
用途:For Research Use Only. Not for use in diagnostic or therapeutic procedures.
相關產品
靶點詳情
-
功能:Key decatenating enzyme that alters DNA topology by binding to two double-stranded DNA molecules, generating a double-stranded break in one of the strands, passing the intact strand through the broken strand, and religating the broken strand. May play a role in regulating the period length of ARNTL/BMAL1 transcriptional oscillation.
-
基因功能參考文獻:
- The highly proliferating C2A subtype of hepatoblastoma is characterized by topoisomerase 2-alpha gene up-regulation and Fanconi anemia pathway activation. PMID: 29152775
- TOP2A protein showed a time dependent influence on prognosis in stage I-II luminal breast cancer, suggesting it might be a potential predictor of late recurrence for this group of patients. PMID: 29587760
- Data indicate that tyrosyl-DNA phosphodiesterase 2 (TDP2) alone does not remove DNA topoisomerase II (TOP2)-DNA complexes from genomic DNA in vitro and that depletion of TDP2 in cells does not slow the removal of TOP2-DNA complexes. PMID: 30011940
- High TOP2A expression and Gene Amplification is associated with Upper Tract Urothelial Carcinomas. PMID: 28755093
- Ki-67 and TOPO 2A expression correlated with tumour size and tumour invasiveness in somatotropinomas. PMID: 29334118
- RNF168 interacts with TOP2alpha to mediate its polyubiquitylation and RNF168 deficiency confers resistance to ICRF-193, a TOP2 catalytic inhibitor, and cytotoxic anti-cancer drug etoposide in cultured mouse cells. PMID: 27558965
- we show that despite being more cytotoxic, F14512 is less efficient than etoposide at producing TOP2alpha cleavage-complex (TOP2alphacc) in cells PMID: 28611105
- our data support further assessment of TOP2A and EZH2 as biomarkers for early identification of patients with increased metastatic potential that may benefit from adjuvant or neoadjuvant targeted therapy approaches PMID: 28899973
- High mRNA levels of TOP2A is independent predictor of poor outcome in Renal Cell Carcinoma patients. PMID: 28069330
- findings implicate TOP2A cleavage as a broad DNA damage mechanism in oncogenic translocations as well as a functional role of TOP2A cleavage in regulating transcription elongation and gene activation. PMID: 28385713
- TOP2A acts as a co-activator of beta-catenin and activates Epithelial-mesenchymal transition process. PMID: 29045811
- ProEx C is an immunohistochemical cocktail containing antibodies direct against topoisomerase IIalpha (TOP2A) and minichromosome maintenance 2 (MCM2) proteins. This brief review covers the effective utility of ProEx C as adjunct tool in assessing the urothelial lesions in urine cytology, also providing prognostic and therapeutic information to help in clinical decisions. PMID: 28638271
- High TOP2A expression was significantly associated with longer time to progression after EDP-M. TOP2A and TS proteins assessed by immunohistochemistry significantly correlated with mRNA expression. Immunohistochemical TOP2A expression was associated with a non-significant better response and longer TTP after EDP-M. PMID: 28432084
- Data show that comparing with Ki-67 and TOP2A, RacGAP1 allowed for a clearer prognostic statement. PMID: 27259241
- These findings reveal a novel, p53-independent activity of Mdm2 and have important implications for the choice of chemotherapeutic agents in the treatment of Mdm2-overexpressing tumors. Herein is shown that tumor cells with MDM2 amplification are selectively resistant to treatment with topoisomerase II poisons but not other DNA damaging agents PMID: 28692049
- The methodology is useful for a high-throughput analysis of drugs that poison Top2, allowing not just the discrimination of the Top2 isoform that is targeted but also to track its removal PMID: 27517472
- TOP2A was identified in association with the progression and prognosis of pancreatic ductal adenocarcinoma probably by regulating cell cycle and p53 signaling pathway. PMID: 28815403
- the relation between TOP2A levels and sensitivity for doxorubicin was examined, confirming reports that TOP2A mRNA levels were overexpressed in MPNST and showing that MPNST cell lines exhibited relatively high TOP2A protein levels and sensitivity to doxorubicin. PMID: 28813519
- The decatenation checkpoint is regulated, not only by topo IIalpha, as previously reported, but also by topo IIbeta. The decatenation checkpoint is most efficient when both isoforms are present. Deletion of most of the C-terminus of topo IIalpha, while preserving the nuclear localization signal (NLS), enhances the decatenation checkpoint and sensitivity to topo II-targeted drugs. Mutation of Y640 in topo IIalpha inhibi... PMID: 28472494
- Tumors with higher topoisomerase IIalpha and/or mitosin expression have a higher risk of recurrence after initial treatment, and these patients may benefit from adjuvant treatment and closer radiological follow-up PMID: 28301542
- Both the genome instability and cell death of MRE11-null and MRE11-mutated H129N cells are significantly reversed by overexpression of Tdp2, an enzyme that eliminates covalent Top2 conjugates; thus, the essential role of Mre11 nuclease activity is likely to remove the DNA lesions. PMID: 27814490
- Topoisomerase-IIalpha expression was identified as a predictor of disease-free survival in high grade papillary urothelial carcinomas. PMID: 27473264
- This study shows that both survivin and TIIalpha are independent prognostic predictors in human grade II/III astrocytomas stratified for IDH1-mutation status PMID: 28214203
- Polyamide functionalisation at the N1-position offers a design strategy to improve drug-like properties. Dicationic HxIP* 3 increased topo IIalpha expression and chemosensitivity to topo II-targeting agents. PMID: 27750031
- These results explain why hTOPIIa and hTOPIIa are differentially affected by various poisons and demonstrate the utility of C. elegans in understanding the genetics of drug responses. PMID: 28700616
- BD ProExtrade mark C assay containing MCM2 and TOP2A antibodies showed strong specific nuclear staining that correlated with increased cervical dysplasia and lesion severity. PMID: 28093271
- Fbxo28 regulates topoisomerase IIalpha decatenation activity and plays an important role in maintaining genomic stability. PMID: 27754753
- TOP2A rs471692 was not associated with chemoradiotherapy response, whereas tumor regression, weight loss, clinical stage, and cigarette smoking were independent prognostic predictors for these Chinese patients with non-small cell lung cancer. PMID: 28231233
- we propose that phosphorylation of TOP2A by CDC7/DBF4 in early S-phase prevents its localization and/or activity at centromeres, and inhibition of TOP2A function could be relevant to prevent premature separation of centromeric DNA. PMID: 27407105
- Data indicate that cortex involvement, lower World Health Organization grade and DNA topoisomerase II positivity were strong predictors for preoperative epileptic seizures. PMID: 28087392
- Alternative RNA Processing of Topoisomerase IIalpha in Etoposide-Resistant Human Leukemia K562 Cells: Intron Retention Results in a Novel C-Terminal Truncated 90-kDa Isoform PMID: 27974648
- Study found an association between TOP2alpha gene amplification and overexpression of its protein in patients with triple-negative breast cancer. PMID: 28393224
- This study showed that the overexpressions of Ki67, RacGAP1, and TOP2a affect the prognosis of female breast cancer patients adversely PMID: 27284123
- TOP2A is highly expressed in advanced leiomyosarcoma (LMS)but not in non-malignant diseases. TOP2A levels are higher in high-mitotic index tumours and in more advanced stages of disease. PMID: 26994023
- TOP2a involvement in breast cancer cells apoptosis PMID: 28075472
- HER2 amplification, but not TOP2A amplification, is a predictor of unfavorable prognosis in breast cancer. PMID: 28079792
- TOP2A and Ki-67 antibodies may be used in combination for cervical cancer screening in immunocytochemistry assays. PMID: 27175798
- The combined quantum and molecular mechanics calculations revealed that CF3 containing drug shows better preference in inhibiting the TOP2A compared to other modified drugs. PMID: 27088089
- Positive expressions of MRP and TOP2A in the tumor tissue are associated with increased risk of developing brain metastases in non-small cell lung cancer (NSCLC). PMID: 26617887
- may be a useful biomarker in patients receiving adjuvant taxane-platinum regimens with moderate- to high-risk endometrial cancer PMID: 26588239
- during early development, TOP2A is likely to have a role in cell proliferation, whereas TOP2B is expressed in post-mitotic cells and may be important in controlling expression of long genes even at this early stage. PMID: 26612825
- Deletion or deficiency of PTEN leads to down regulation of TOP2A, dysfunction of the decatenation checkpoint and incomplete DNA decatenation in G2 and M phases. PMID: 26657567
- The study is an open label, single arm, phase II study, investigating the efficacy of epirubicin in patients with oxaliplatin refractory colorectal cancer and with a cancer cell TOP2A/CEN-17 ratio >/= 1.5 PMID: 26867764
- These studies revealed a relationship between TOP2A and androgen receptor signaling pathway that contributes to prostate cancer progression and confers sensitivity to treatments. PMID: 26560244
- TUBB3, TOP2A, CYP19A1 and CYP2D6 gene expression, but not protein expression, was associated with patient survival in breast cancer . PMID: 26252353
- PICH and Topo II cooperate to prevent chromosome missegregation events in mitosis. PMID: 26643143
- Topoisomerase IIalpha, an enzyme essential for resolution of DNA replication intermediates, binds telomeres in a TRF1-mediated manner. PMID: 24626180
- Mutation in TOP2A gene is associated with epithelial ovarian cancer growth and drug resistance. PMID: 25846551
- Patients screened for Top2a and Ezh2 expression would exhibit significant response to a combinational treatment involving low dose etoposide combined with Ezh2 inhibition. PMID: 25605014
- It might, therefore, be concluded that topoisomerase II enzyme may be involved in the repair of radiation-induced DNA damage and consequently its inhibition constitute a strategy for sensitizing tumour cells to ionizing radiation. PMID: 26081617
顯示更多
收起更多
-
亞細胞定位:Cytoplasm. Nucleus, nucleoplasm. Nucleus. Nucleus, nucleolus.
-
蛋白家族:Type II topoisomerase family
-
組織特異性:Expressed in the tonsil, spleen, lymph node, thymus, skin, pancreas, testis, colon, kidney, liver, brain and lung. Also found in high-grade lymphomas, squamous cell lung tumors and seminomas.
-
數據庫鏈接:
Most popular with customers
-
-
YWHAB Recombinant Monoclonal Antibody
Applications: ELISA, WB, IHC, IF, FC
Species Reactivity: Human, Mouse, Rat
-
Phospho-YAP1 (S127) Recombinant Monoclonal Antibody
Applications: ELISA, WB, IHC
Species Reactivity: Human
-
-
-
-
-